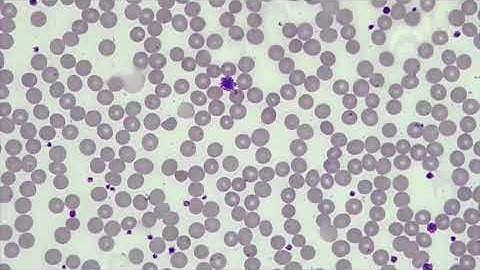
WBC Differential, WBC/PLT Estimate, RBC Morphology

⬇ DOWNLOAD NOW
Kalau muncul iklan pop-up, tutup lalu klik tombol kembali
Download lagu Manual Platelet Count - Slide Method secara gratis hanya untuk keperluan promosi. Dukung artis favorit kamu dengan membeli musik original di iTunes atau platform resmi lainnya.
 Complete blood count Slide With Normal platelets under microscope 🔬
Complete blood count Slide With Normal platelets under microscope 🔬
 Platelets seen under microscope in peripheral blood smear.How to count manually from blood smear.
Platelets seen under microscope in peripheral blood smear.How to count manually from blood smear.
 Manual platelet count - hemocytometer Procedure | Calculation | interpretation
Manual platelet count - hemocytometer Procedure | Calculation | interpretation
 Platelet count by simple manually slide method || Hematology
Platelet count by simple manually slide method || Hematology
 Manual platelet count slide method | Platelets count on smear
Manual platelet count slide method | Platelets count on smear
 Platelet count of Blood #hereditybioacademy #reels
Platelet count of Blood #hereditybioacademy #reels
 Manual platelet count by slide method#calculations
Manual platelet count by slide method#calculations
WBC Differential, WBC/PLT Estimate, RBC Morphology
WBC Differential, WBC/PLT Estimate, RBC Morphology